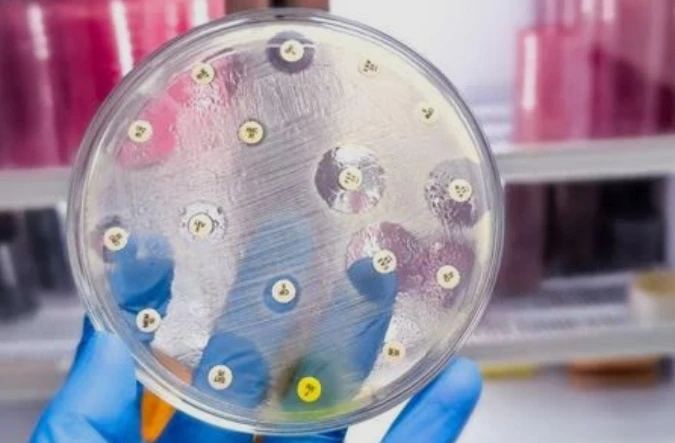
Culture & Sensitivity - Prostatic

تفاصيل التحليل
مزرعة وحساسية إفرازات البروستاتا
فحص متخصص لتشخيص أسباب التهاب البروستاتا وتحديد البكتيريا المسببة لصعوبة التبول أو الألم، مما يوجه الطبيب نحو المضاد الحيوي الأكثر فعالية لعلاج الحالة من جذورها.
الصورة التوضيحية المرتبطة بهذا التحليل